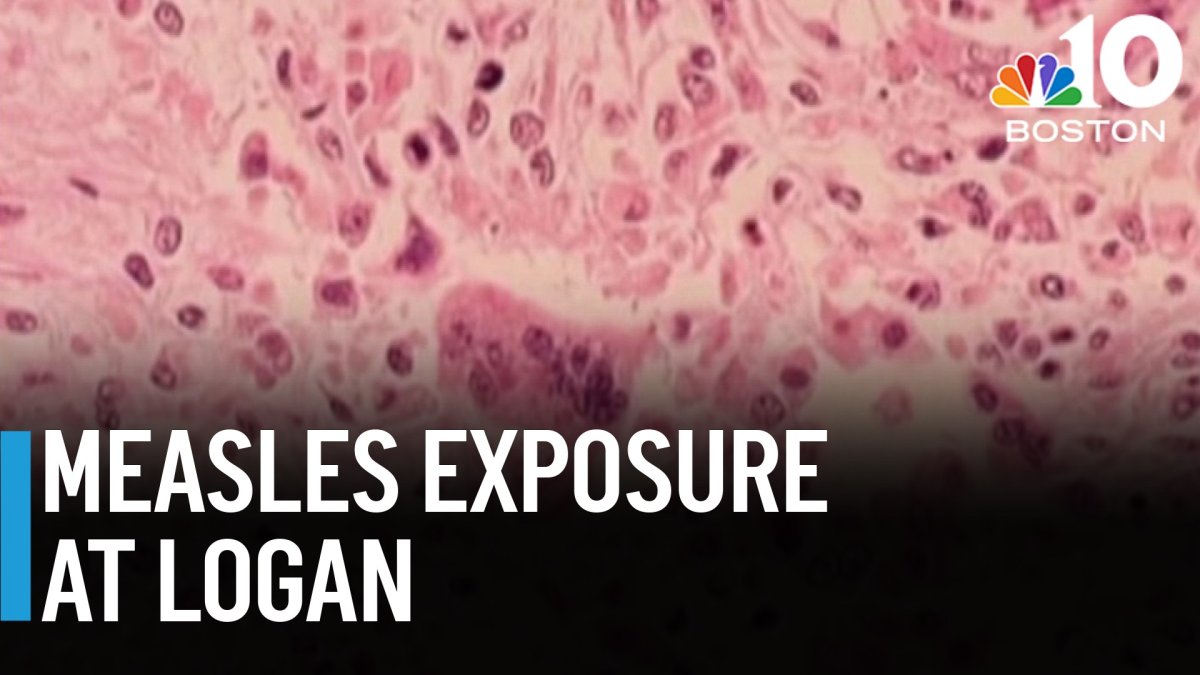

The April 14, 2026 measles exposure incident at Boston Logan International Airport—where an infected JetBlue Airways passenger (Flight 470 from Fort Lauderdale) passed through Terminal C between midnight and 2:30 a.m.—represents a critical operational risk signal for cross-border e-commerce sellers managing international shipments through this major logistics hub. The Boston Public Health Commission and Massachusetts Department of Public Health identified potential exposure for terminal visitors and flight passengers, with health officials requiring unvaccinated individuals to avoid public places including workplaces and stores for 21 days (through May 5, 2026). Massachusetts has recorded two confirmed measles cases among residents in 2026, reflecting declining vaccination rates that reduce population immunity according to Dr. Richard Ellison of UMass Memorial Medical Center.
For cross-border e-commerce operations, this incident directly impacts supply chain continuity and workforce management. Boston Logan serves as a critical air freight hub for international sellers shipping to North America, particularly for electronics, apparel, and specialty goods categories. The measles exposure creates three operational vulnerabilities: (1) Personnel availability disruption—unvaccinated logistics workers, customs brokers, and 3PL staff may face 21-day work restrictions if exposed, reducing terminal processing capacity; (2) Enhanced cleaning protocols—Massport implemented additional terminal sanitization procedures that can delay cargo processing by 4-8 hours during peak periods; (3) Health screening requirements—international air freight may face enhanced health documentation requirements, adding 1-2 business days to customs clearance timelines. Sellers managing time-sensitive shipments (perishables, seasonal inventory, just-in-time fulfillment) face potential delays of 3-7 days if personnel shortages or enhanced protocols activate.
The broader context reveals systemic supply chain vulnerability to infectious disease events. The incident demonstrates how quickly infectious diseases spread across state lines through air travel networks—the infected individual traveled from Fort Lauderdale through Boston to out-of-state destinations, creating multi-state exposure chains. For sellers relying on Boston Logan for 40-60% of Northeast distribution, alternative logistics planning becomes critical. Sellers should immediately audit their 3PL provider vaccination rates, establish backup fulfillment routes through alternative hubs (Newark, Philadelphia, New York JFK), and implement health monitoring protocols for logistics personnel. The incident also signals potential demand surge for health-related products: medical masks, sanitizers, thermometers, and vaccination-related merchandise may see 15-25% traffic increases during public health alert periods, creating short-term selling opportunities in health and wellness categories on Amazon, eBay, and Shopify platforms.